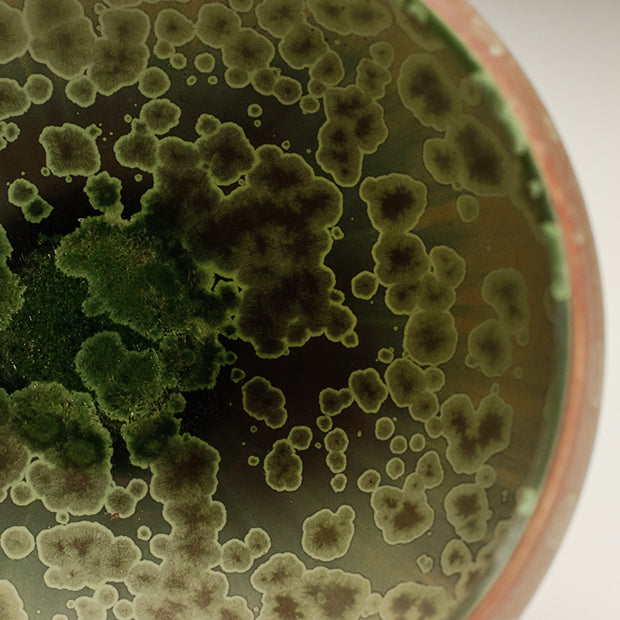

- Maker
- andrew krueger
- PIECE
- Bowl
Description
Porcelain, Matte Zinc Crystalline Glaze, Wheel Thrown, Cone 9, Oxidation.
- MEDIUMClay
- HEIGHT X WIDTH X DEPTH4x6.5x6.5 Inches
- MATERIALSPorcelain
- MARKED/SIGNED Yes
- METHODThrown
- PRICE
Regular price $150.00Regular priceUnit price per
- FIRINGElectric
- PIECE CODEKRUA0033
Couldn't load pickup availability